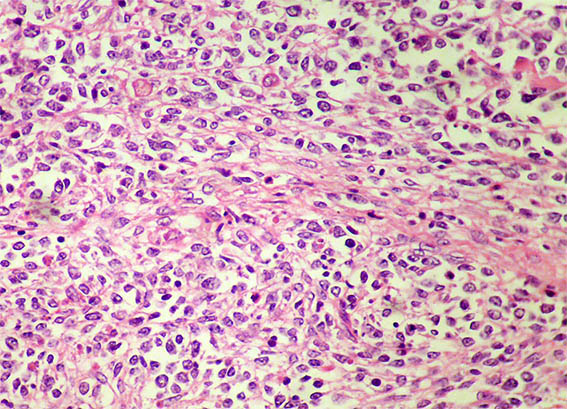

|
|
CASO
216 (febrero de 2024)
Datos clínicos:
Un niño de 4 años de edad presenta masa renal derecha que reemplaza el riñón en un 70%. Con impresión diagnóstica de tumor de Wilms se inicia quimioterapia preoperatoria. Luego de un mes de tratamiento no parece haber adecuada respuesta y se hace nefrectomía. No hay antecedentes personales patológicos. No hay lesiones extrarrenales.
Observe las imágenes.

Figura 1.

Figura 2. Imagen con mayor acercamiento.

Figura 3.
H&E, X100.

Figura 4. H&E, X200.

Figura 5. H&E, X400.
Figura 6. H&E, X400.

Figura 7. H&E, X400.

Figura 8. H&E, X400.

Figura 9. H&E, X400.

Figura 10. H&E, X400.

Figura 11. Inmunohistoquímica para WT1 completamente negativa, X400.

Figura 12. Inmunohistoquímica para Ciclina D1: positividad nuclear difusa, X400.
Miogenina, CD99, CD45, S100, cromogranina, sinaptofisina, citoqueratinas: Negativas. INI1: positividad nuclear difusa.
¿Cuál es su diagnóstico?
Ver
diagnóstico y discusión
[Arriba]
|
|